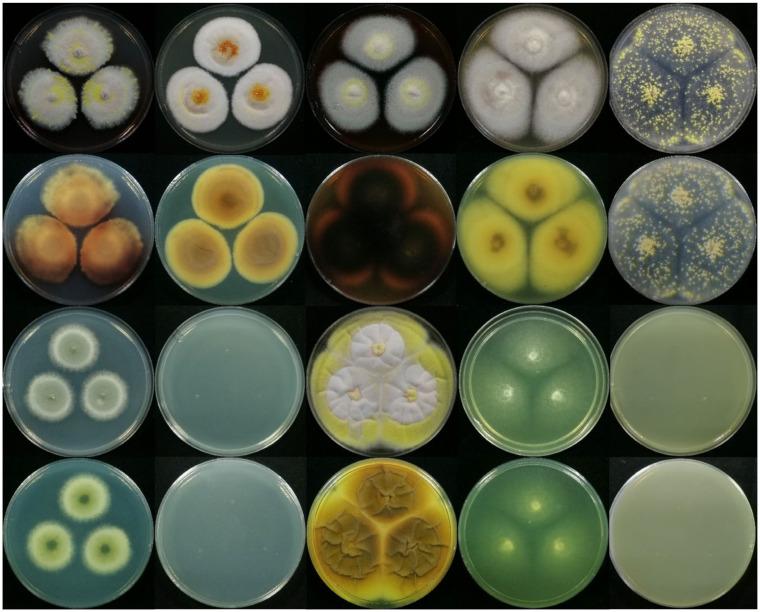
https://cdn.ncbi.nlm.nih.gov/pmc/blobs/d9e5/8877249/00f9d22949cd/jof-08-00155-g005.jpg
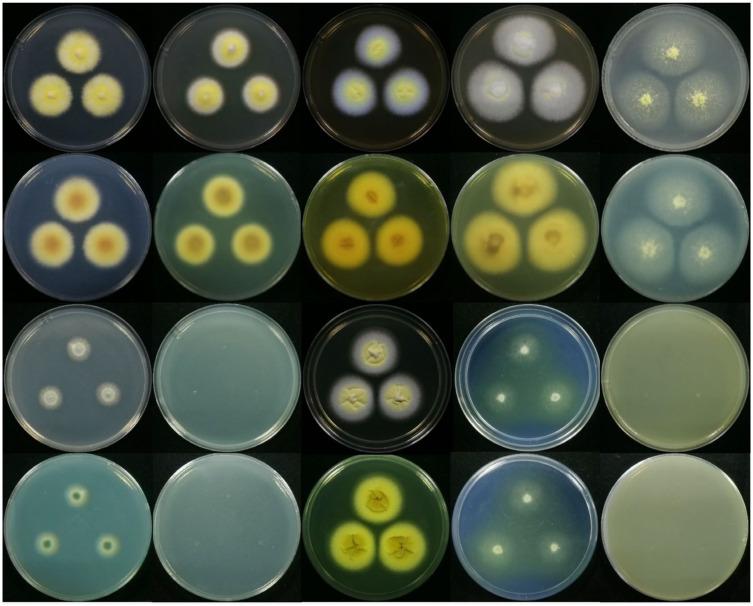
https://cdn.ncbi.nlm.nih.gov/pmc/blobs/d9e5/8877249/54ea9c178bd4/jof-08-00155-g004.jpg

马尾松根际土壤中一种新型有益真菌物种的精细鉴定与分类
Fine Identification and Classification of a Novel Beneficial Fungal Species from Masson Pine Rhizosphere Soil.
作者信息
Sun Xiao-Rui, Xu Ming-Ye, Kong Wei-Liang, Wu Fei, Zhang Yu, Xie Xing-Li, Li De-Wei, Wu Xiao-Qin
机构信息
Co-Innovation Center for Sustainable Forestry in Southern China, College of Forestry, Nanjing Forestry University, Nanjing 210037, China.
The Connecticut Agricultural Experiment Station Valley Laboratory, Windsor, CT 06095, USA.
出版信息
J Fungi (Basel). 2022 Feb 3;8(2):155. doi: 10.3390/jof8020155.
Rhizosphere fungi have the beneficial functions of promoting plant growth and protecting plants from pests and pathogens. In our preliminary study, rhizosphere fungus JP-NJ4 was obtained from the soil rhizosphere of and selected for further analyses to confirm its functions of phosphate solubilization and plant growth promotion. In order to comprehensively investigate the function of this strain, it is necessary to ascertain its taxonomic position. With the help of genealogical concordance phylogenetic species recognition (GCPSR) using five genes/regions (ITS, , , , and ) as well as macro-morphological and micro-morphological characters, we accurately determined the classification status of strain JP-NJ4. The concatenated phylogenies of five (or four) gene regions and single gene phylogenetic trees (ITS, , , , and genes) all show that strain JP-NJ4 clustered together with and , but differ markedly in the genetic distance (in gene) from type strain and multiple collections of . and . . The morphology of JP-NJ4 largely matches the characteristics of genes , and the rich and specific morphological information provided by its colonies was different from that of and . In addition, strain JP-NJ4 could produce reduced conidiophores consisting of solitary phialides. From molecular and phenotypic data, strain JP-NJ4 was identified as a putative novel fungal species, designated .
根际真菌具有促进植物生长以及保护植物免受害虫和病原体侵害的有益功能。在我们的初步研究中,根际真菌JP-NJ4是从[具体植物名称]的土壤根际中获得的,并被选作进一步分析以确认其解磷和促进植物生长的功能。为了全面研究该菌株的功能,有必要确定其分类地位。借助使用五个基因/区域(ITS、[此处原文缺失部分基因名称]、[此处原文缺失部分基因名称]、[此处原文缺失部分基因名称]和[此处原文缺失部分基因名称])的系统发育一致性系统发育物种识别(GCPSR)以及宏观形态和微观形态特征,我们准确地确定了菌株JP-NJ4的分类地位。五个(或四个)基因区域的串联系统发育树和单基因系统发育树(ITS、[此处原文缺失部分基因名称]、[此处原文缺失部分基因名称]、[此处原文缺失部分基因名称]和[此处原文缺失部分基因名称]基因)均表明,菌株JP-NJ4与[相关物种名称1]和[相关物种名称2]聚集在一起,但在遗传距离(在[具体基因名称]基因中)上与模式菌株以及[相关物种名称1]和[相关物种名称2]的多个分离株有显著差异。JP-NJ4的形态在很大程度上与[相关基因名称]基因的特征相匹配,其菌落提供的丰富且特定的形态信息与[相关物种名称1]和[相关物种名称2]不同。此外,菌株JP-NJ4可产生由单个瓶梗组成的缩短的分生孢子梗。根据分子和表型数据,菌株JP-NJ4被鉴定为一个假定的新型[真菌属名称]真菌物种,命名为[新物种名称]。